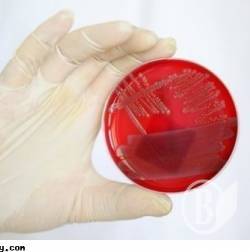
...

Повар отравил детей налистниками... В «Радуге» карантин
20 человек, из них 16 детей и 4 взрослых (2 учителей, 2 работника пищеблока) состоянием на 18 июня пострадали в лагере отдыха «Радуга» с дневным пребыванием на базе Носовской ООШ I-III ст. № 2.
Здесь зафиксировали вспышку сальмонеллеза.
Об этом"Высокому Валу"сообщил представитель государственной санитарно-эпидемиологической службы Черниговской области.
Из всех заболевших 4 детей и взрослые обнаружены активно при медицинских осмотрах и по результатам бакобследования.
12 детей, 4 взрослых госпитализированы в инфекционное отделение Носовской ЦРБ, еще 4-ре ребенка находится на амбулаторном лечении, ход заболевания легкой и средней тяжести, всем назначено соответствующее лечение.
Госсанэпидслужба в Черниговской области в пределах своей компетенции проводит противоэпидемические мероприятия в полном объеме.
По предшествующим данным эпидрассследования источником инфекции является повар (результаты серологического и бактериологического обследования), фактор передачи - готовые блюда (блины с кисломолочным сыром, которые были приготовлены с нарушением технологии без повторной термической обработки и входили в меню лагеря 10. 06. 2014 г.) ; обстоятельства, которые способствовали возникновению вспышки, - нарушение санитарно-гигиенических требований, технологических правил при приготовлении блюд, дезрежима на пищеблоке.
Эпидрасследование, противоэпидемические мероприятия и лабораторные исследования продолжаются.
Ситуация по этому вопросу находится на контроле Главного управления ГСЭС Украины в Черниговской области.
| Версия для печати Отправить по e-mail Обсудить на форуме |
| Просмотров : 6272 |
Ссылки по теме:
16.06.2014 В «зеркало душе» осужденных заглянули окулисты
13.06.2014 Светлый праздник – в светлой больнице – фото
16.06.2014 Кровавая «санта-барбара» с «белой горячкой» в Чернигове







































Добавить комментарий: